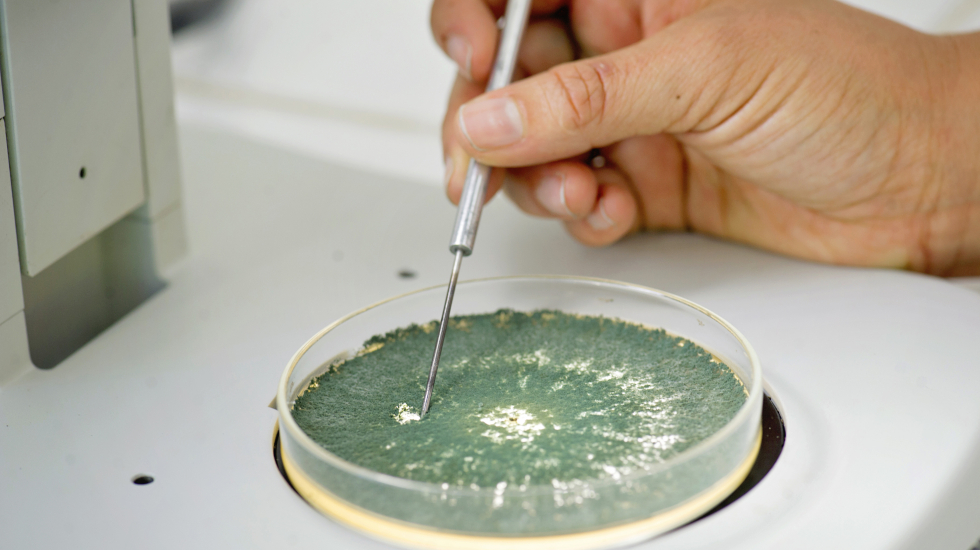

Noticias
Costa Rica necesita más ciencia local para adaptarse al cambio climático

Para Costa Rica, el cambio climático es una realidad y la adaptación a este, entendida como aquellas estrategias orientadas a reducir los riesgos, una necesidad imperativa. Ante ello, la ciencia puede brindar insumos para diseñar acciones que sean efectivas y maximicen la inversión en un país donde los fondos no abundan.
Si bien los informes elaborados por el Panel Intergubernamental sobre Cambio Climático (IPCC) buscan servir de guía a los países, lo cierto es que Centroamérica -y Costa Rica dentro de esta- se diluye entre los datos de América Latina.
“En el IPCC tenemos el gran reto de enfocarnos más en las subsecciones dentro de las grandes regiones. Estamos conscientes de ello porque sabemos que muchos países necesitan esa información para tomar decisiones”, comentó Jonathan Lynn, jefe de Comunicación y Relaciones Públicas del IPCC.
No es solo eso, lo cierto es que la cantidad de producción científica de Centroamérica -y, por ende, Costa Rica- no es equiparable a la de otros grandes países de Latinoamérica -como Argentina o Brasil- y ciertamente es mucho menor a la de Europa o Estados Unidos.
El IPCC evalúa el avance del conocimiento, es decir, se revisa literatura científica publicada hasta ese momento en revistas arbitradas (que tienen revisión de pares), informes de política pública y otro tipo de literatura gris (como reportes, tesis académicas, etc). En otras palabras, el IPCC requiere que se generen estudios para poder incluirlos en sus informes de evaluación.
“Otro de los vacíos es que si bien conocemos de estrategias de adaptación que se aplican en la región y algunas de mitigación, lo que nos falta conocer todavía es cómo complementar estas medidas de mitigación y adaptación de forma conjunta para poder evaluar las sinergías que se producen en nuestra región. La experiencia hasta ahora ha sido aplicar una estrategia de adaptación cuyo co-beneficio asociado sea la mitigación”, destacó Inés Camilloni, autora del informe especial sobre 1,5 y 2 ºC del IPCC y doctora por la Universidad de Buenos Aires en el área de Ciencias de la Atmósfera.
“A partir de los hallazgos del quinto reporte de evaluación del IPCC, nos dimos cuenta que hay grandes vacíos de información en torno a qué es lo que debemos y podemos hacer en referencia a la reducción de la vulnerabilidad y el riesgo y, por ende, a la construcción de capacidades de las poblaciones y las instituciones”, explicó Fernando Aragón Durango, también autor del informe especial del IPCC e investigador del Programa de Estudios Avanzados en Desarrollo Sustentable y Medio Ambiente del Colegio de México.
¿Cuáles vacíos de información? Aragón puso un ejemplo: es necesario pensar en qué términos la infraestructura básica de las ciudades puede afrontar eventos meteorológicos extremos al 2030 y, en este sentido, cómo se debe comunicar el riesgo, cuáles serían los impactos y las posibilidades de construir medidas de adaptación entre las comunidades, los científicos y funcionarios de gobierno.
“Con estos informes del IPCC, tenemos una idea más clara de hacia dónde enfocar la producción de conocimiento para que este sirva a la toma de decisiones. No obstante, las agendas nacionales de ciencia y producción de conocimiento deberán reflejar la necesidad por llenar estos vacíos en cuanto a vulnerabilidad, riesgo, impacto, adaptación y mitigación”, destacó Aragón en una entrevista concedida a LatinClima con motivo del lanzamiento del informe del IPCC en que participó.
Lamentablemente, eso no está pasando. La producción científica y la generación de políticas están desvinculadas.
Las consecuencias de la desvinculación
El proyecto LatinoAdapta se implementa en seis países latinoamericanos: Argentina, Brasil, Chile, Paraguay, Uruguay y Costa Rica. Busca reducir las brechas de conocimientos existentes y fortalecer las capacidades de los políticos para así planificar e implementar acciones óptimas en pro de la adaptación.
En este sentido, los investigadores realizaron diagnósticos de brechas de conocimiento y resúmenes de políticas, los cuales se socializaron en el marco de la 25 Conferencia de las Partes de la Convención Marco de Naciones Unidas sobre Cambio Climática (COP25) que tiene lugar en la ciudad de Madrid, en España, del 2 al 13 de diciembre.
El diagnóstico de Costa Rica -elaborado por la investigadora Mariela Morales del Centro Agronómico Tropical de Investigación y Enseñanza (CATIE)- reveló que la mayoría de los entrevistados (77%) aducen que existe un déficit de información, el cual afecta el desarrollo y la implementación de las medidas de adaptación.
Ese déficit informativo se refiere a los impactos del cambio climático, la efectividad de diferentes opciones de adaptación y los costos-beneficios de las diferentes opciones de adaptación. También se requiere información vinculada a la vulnerabilidad social y ambiental así como a las proyecciones climáticas a largo plazo.
En cuanto a la producción científica como tal, el diagnóstico indicó que existe poca transparencia en los métodos para la obtención de datos y cálculos, así como un débil aprovechamiento de las redes científicas internacionales que operan en Costa Rica.
.png)
Tampoco existen líneas base que sean robustas, lo cual impide evaluar los cambios y los impactos de forma eficiente. A esto se suma que no existen indicadores claros sobre cómo evaluar la efectividad de las medidas de adaptación. Las instituciones gubernamentales ni siquiera cuentan con un sistema de monitoreo y gestión del conocimiento adecuado.
“Se sabe que hay muchas acciones que se realizan para aportar a las Contribuciones Nacionalmente Determinadas (NDC). Sin embargo, estas acciones no son tabuladas ya que la métrica de las acciones de cambio climático aún no es clara. No existe una guía de cómo reportar las acciones, se desconoce quién es el responsable (o dónde obtener asesoramiento) y no ha habido ningún tipo de retroalimentación entre los reportes realizados. Tampoco hay difusión correcta de los mecanismos existentes”, se señala en el informe.
Sumado a esto, las instancias de generación de conocimiento (como universidades o centros de investigación) no visualizan al usuario de la información (por ejemplo, el gobierno o municipalidades) y, por tanto, desconocen cuáles son sus necesidades de información.
“En cuanto a los usuarios del conocimiento, casi que no forman parte en la decisión de las agendas de investigación. Esta distancia genera un vínculo débil entre el usuario y la academia”, se lee en el diagnóstico.
Asimismo, si bien el conocimiento debe ser técnicamente robusto, también debe ser entendible y utilizable. “De lo contrario, el conocimiento pierde su razón de ser. El reto va más allá de la ciencia y tiene que ver con la parte más pedagógica, más de transmisión, sin sacrificar el rigor científico”, señala el informe.
De hecho, la información sobre escenarios climáticos futuros a nivel nacional y local está disponible en Costa Rica, pero esta es utiliza en pocas instancias “para orientar la planificación territorial y la asignación de los recursos económicos y humanos necesarios para implementar medidas de adaptación al cambio climático”.
Eso deriva en una pobre apropiación y uso del conocimiento. Un ejemplo de ello, aportado por el informe de LatinoAdapta, está dado a nivel subnacional o municipal. Si bien el Instituto Meteorológico Nacional (IMN) genera datos climáticos -como cuánto han aumentado las emisiones o cuáles han sido las pérdidas o daños por eventos extremos-, las municipalidades no son capaces de traducir esa “información científica en una acción predictiva dentro de la comunidad local, en su planificación territorial o en los planes reguladores”.
“Necesitamos invertir en el fortalecimiento de capacidades de los investigadores locales y su vinculación a nivel político, sino nos vamos a sentar sobre un montón de tecnologías y datos que nadie va a usar”, comentó Santiago Alba-Corral, director interino de Agricultura y Medioambiente del Centro Internacional de Investigaciones para el Desarrollo (IDRC, por sus siglas en inglés).
.png)
En este sentido, los entrevistados en el diagnóstico de LatinoAdapta proponen que “se debería realizar una planificación global que permita identificar necesidades de investigación de manera integrada y constituir mesas de diálogo interinstitucionales para fijar objetivos en común. A su vez, el Gobierno central debe delinear y socializar objetivos enfocados en el tema del cambio climático, así como indicar qué información se requiere para lograrlos”.
Asimismo, en el país existe poca coordinación entre instituciones, lo cual se traduce en duplicidad de gastos y recursos. Pero, además, existen limitaciones presupuestarias que conducen al recorte de fondos destinados al fortalecimiento de los recursos humanos y tecnológicos necesarios para generar conocimiento sobre el clima.
Igualmente, los criterios e instrumentos -centrados en la protección ambiental y la gestión local de riesgo- están ausentes, lo cual impide incorporar medidas de adaptación en planes de inversión pública y desarrollo tanto a nivel territorial como local.
Además, el diagnóstico identificó que existe una desconexión institucional con la realidad en el campo y una desvinculación mayor entre instituciones del Estado, académicas y privadas. Además, no existe una política clara que incorpore el cambio climático en todos los proyectos y exija su cumplimiento.
“En general, hay poca claridad sobre qué visión tiene el país en el tema del cambio climático. No se aprovechan las nuevas tecnologías de la información, existe un costo alto de transferencia de datos y no hay una planificación eficiente en la generación del conocimiento”, indica el informe.
Esta realidad no es exclusiva de Costa Rica. “En América Latina invertimos más en antibióticos en vez de vacunas”, dijo Alba-Corral refiriéndose a la tendencia de atender las emergencias en lugar de prevenirlas
Para Pilar Bueno, co-presidenta de Adaptación de la Convención Marco de las Naciones Unidas sobre el Cambio Climático, se debe partir desde lo comunitario e ir permeando otros niveles hasta alcanzar el nacional.
.png)
Asimismo, y en ese mismo espíritu, en la COP25 se viene hablando de la importancia de incorporar el conocimiento local e indígena en el engranaje científico para que brinda insumos a los gobernantes para la toma de decisiones. Lo mismo con respecto a las ciencias sociales más allá de la economía.
Participación de la ciencia en la acción climática
“Todo lo que vayamos a hacer en acción climática, hay que medirlo y todo lo que vamos a medir, solo podremos medirlo basado en la información generada por el país”, declaró el ministro de Ambiente y Energía de Costa Rica, Carlos Manuel Rodríguez.
Para Rodríguez, contar con información científica es clave para orientar las políticas de adaptación pero también para accesar a recursos financieros. Los datos sirven no solo para rendir cuentas de la inversión y la efectividad de esta sino para fortalecer la transparencia.
“Necesitamos institucionalizar la métrica”, dijo Rodríguez y agregó: “No solo eso. En acción climática, necesitamos afinar el lapicero en tres direcciones: carbono, biodiversidad y agua. Desde el satélite yo puedo ver cómo se expande un cultivo, pero para conocer la salud del ecosistema del que soy responsable, me faltan datos”.
“Cuando me preguntan cuál es el estado de la biodiversidad, no puedo responder de la misma forma que sí lo haría el ministro de Hacienda cuando le preguntan sobre el estado de la economía. A eso tenemos que llegar y ya estamos trabajando en esta materia a través del Centro Nacional de Información Geoambiental (CENIGA) y el Sistema Nacional de Métrica en Cambio Climático (SINAMECC)”, comentó Rodríguez.
Asimismo, el ministro de ambiente ve un beneficio más: los datos científicos también sirven para medir el desempeño de las políticas, las sinergias institucionales e incluso de los funcionarios públicos. “El ciudadano costarricense tiene que tener un sistema de información veraz para medir la gestión política. Que hablen los datos”, recalcó el ministro.
En sus Contribuciones Nacionalmente Determinadas (NDC, por sus siglas en inglés), Costa Rica incluyó un novedoso mecanismo de participación: el Consejo Científico de Cambio Climático, más conocido como el 4C.
El 4C es un espacio deliberativo, reconocido formalmente por el Estado a través de un decreto ejecutivo, cuyas recomendaciones no son vinculantes. Su objetivo es asesorar y guiar al Consejo Sectorial de Ambiente, en particular al ministro. Está integrado por académicos y expertos nacionales e internacionales, así como funcionarios del IMN, Instituto Nacional de Tecnología Agropecuaria (INTA), Consejo Nacional de Rectores (CONARE) y CENIGA.
“La motivación inicial de esto era acompañar el trabajo del gobierno, tanto del ministro como la Dirección de Cambio Climático (DCC) y el IMN, en el seguimiento de los avances en el cumplimiento del Acuerdo de París en lo referente a métrica”, explicó Pascal Girot, quien es uno de los investigadores miembros del 4C.
Sobre los temas que se discuten en este consejo, algunos son planteados por el gobierno y otros son propuestos por los propios miembros en torno a necesidades científicas para, precisamente, depurar cada vez más la métrica.
Según explicó Girot, la idea es que los miembros del 4C puedan convocar a otros científicos para ampliar el panel de discusión en temas específicos. “Creo que eso le da más robustez al gobierno de Costa Rica para medir sus avances y así afinar la puntería en cuanto a los inventarios de gases de efecto invernadero o las mediciones en los niveles de vulnerabilidad tanto a nivel local como nacional, también permite trabajar los factores de emisión en el sector agropecuario, por ejemplo”.
Asimismo, el investigador agregó: “Esos son trabajos de investigación que redes de científicos a nivel internacional también pueden aprovechar, porque la idea es que el 4C pueda activar esas redes de cooperación científica para resolver ciertos problemas. El fin es que podamos ser un músculo científico-técnico que pueda resolver problemas de métrica, metodologías de análisis… Creo que el 4C es un espacio que, si lo aprovechamos bien, puede potenciar el trabajo en cambio climático”.
Girot considera que el 4C puede convertirse en un foro de discusión para definir prioridades de investigación e incidir en la agenda científica de las universidades públicas o privadas del país. También se pueden movilizar recursos financieros, tecnológicos y humanos provenientes de redes de científicos internacionales “para aumentar el caudal de investigaciones para así tomar mejores decisiones”.
“Lo que tenemos que evitar es tener un doble discurso en el sentido que ya existen instituciones científicas del Estado -como el IMN y el INTA- que trabajan en temas muy técnicos y tener al 4C como una segunda voz disonante. La idea es poder trabajar de la mano y no en forma paralela”, recalcó Girot.
Una cuestión más que está en el norte del 4C, según Girot, es darle continuidad al trabajo en cambio climático más allá de quien está ocupando la silla del ministro.
Esta información fue producida como parte del Programa Latinoamericano de Cobertura Periodística COP25.